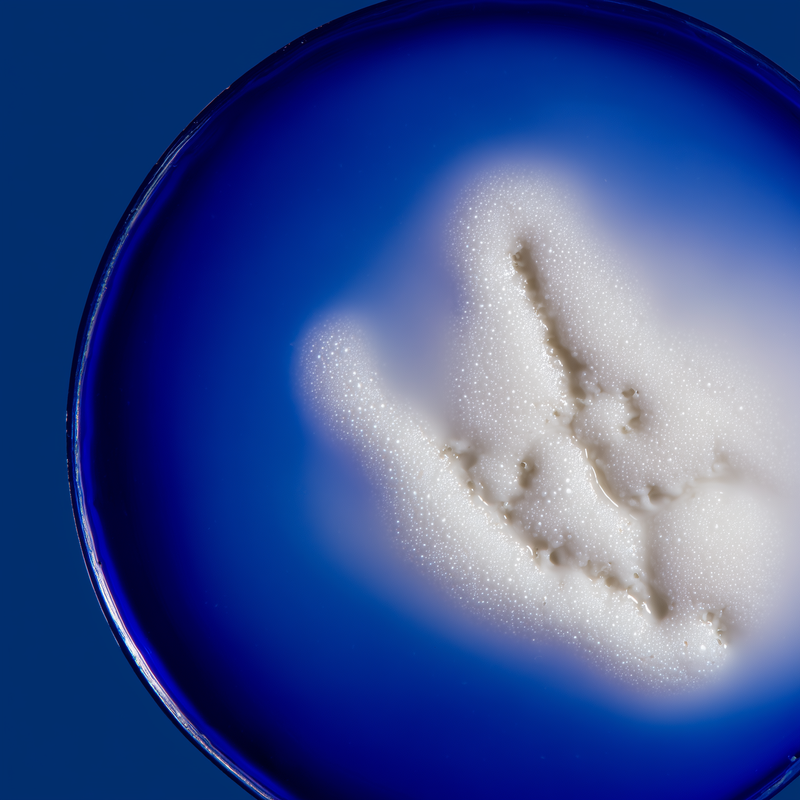

300+
Mujeres
30 - 60
Grupo de edad
Más de 300 personas durante 3 meses
Estos son los resultados resumidos
RESULTADOS FINALES
94%
brotes controlados
95%
tono unificado
95%
marcas y manchas difuminadas
LA CIENCIA DETRÁS DEL PACK
1. Control de brotes
LUMINOSA está formulado para contribuir a la modulación de la inflamación desde el eje intestino-piel mediante 6 cepas probióticas específicas (150 mil millones UFC) que pueden ayudar a reducir citoquinas proinflamatorias como IL-6 y TNF-α. Las vitaminas del complejo B contribuyen a regular la producción sebácea mientras que zinc y selenio ayudan a modular la respuesta inmunitaria cutánea. Esta aproximación desde el intestino está diseñada para abordar la causa raíz de los brotes recurrentes.
2. Marcas y manchas
DIFUMINADA aporta 9 antioxidantes específicos que están diseñados para trabajar sinérgicamente: los extractos de helecho y pino marítimo pueden contribuir a la fotoprotección natural desde el interior, mientras que vitamina C ayuda a los procesos de renovación celular y puede favorecer la uniformidad del tono. Los extractos de uva y astaxantina contribuyen a neutralizar radicales libres que podrían perpetuar la hiperpigmentación. Esta combinación está formulada para ayudar a difuminar manchas existentes mientras protege contra la formación de nuevas

3. Hidratación y Firmeza
HIDRATADA está diseñado para contribuir a la regeneración nocturna mediante ceramidas Ceramosides™ que refuerzan la barrera lipídica y ácido hialurónico que puede atraer y mantener hasta 1000 veces su peso en agua. La melatonina contribuye a optimizar los ciclos circadianos de reparación celular, mientras que aloe vera puede favorecer la síntesis natural de colágeno y ashwagandha ayuda a reducir el cortisol que podría interferir con la regeneración. Esta sinergia está formulada para maximizar el potencial regenerativo nocturno
4. eje intestino-piel
El protocolo está diseñado para actuar de manera integral en el eje intestino-piel: LUMINOSA aporta 6 cepas probióticas específicas que contribuyen al reequilibrio de la microbiota intestinal, pueden ayudar a fortalecer la barrera mucosa y contribuir a modular la comunicación entre intestino y piel. Esta aproximación desde el origen se complementa con la protección antioxidante de DIFUMINADA durante el día y la regeneración profunda de HIDRATADA durante la noche, creando un sistema de 24 horas que puede contribuir a restablecer el equilibrio cutáneo de manera sostenible
1. Control de brotes
LUMINOSA está formulado para contribuir a la modulación de la inflamación desde el eje intestino-piel mediante 6 cepas probióticas específicas (150 mil millones UFC) que pueden ayudar a reducir citoquinas proinflamatorias como IL-6 y TNF-α. Las vitaminas del complejo B contribuyen a regular la producción sebácea mientras que zinc y selenio ayudan a modular la respuesta inmunitaria cutánea. Esta aproximación desde el intestino está diseñada para abordar la causa raíz de los brotes recurrentes.
2. Marcas y manchas
DIFUMINADA aporta 9 antioxidantes específicos que están diseñados para trabajar sinérgicamente: los extractos de helecho y pino marítimo pueden contribuir a la fotoprotección natural desde el interior, mientras que vitamina C ayuda a los procesos de renovación celular y puede favorecer la uniformidad del tono. Los extractos de uva y astaxantina contribuyen a neutralizar radicales libres que podrían perpetuar la hiperpigmentación. Esta combinación está formulada para ayudar a difuminar manchas existentes mientras protege contra la formación de nuevas

3. Hidratación y Firmeza
HIDRATADA está diseñado para contribuir a la regeneración nocturna mediante ceramidas Ceramosides™ que refuerzan la barrera lipídica y ácido hialurónico que puede atraer y mantener hasta 1000 veces su peso en agua. La melatonina contribuye a optimizar los ciclos circadianos de reparación celular, mientras que aloe vera puede favorecer la síntesis natural de colágeno y ashwagandha ayuda a reducir el cortisol que podría interferir con la regeneración. Esta sinergia está formulada para maximizar el potencial regenerativo nocturno
4. eje intestino-piel
El protocolo está diseñado para actuar de manera integral en el eje intestino-piel: LUMINOSA aporta 6 cepas probióticas específicas que contribuyen al reequilibrio de la microbiota intestinal, pueden ayudar a fortalecer la barrera mucosa y contribuir a modular la comunicación entre intestino y piel. Esta aproximación desde el origen se complementa con la protección antioxidante de DIFUMINADA durante el día y la regeneración profunda de HIDRATADA durante la noche, creando un sistema de 24 horas que puede contribuir a restablecer el equilibrio cutáneo de manera sostenible
- Tomar 1 cápsula de LUMINOSA + 2 cápsulas de DIFUMINADA juntas idealmente por la tarde o noche acompañada de un vaso de agua para evitar molestias gástricas. Para uso continuado sin necesidad de pausas.
- Tomar 1 cápsula de HIDRATADA 30-45 minutos antes de dormir con un vaso de agua.
- Protocolo diseñado para uso continuado sin necesidad de pausas. Para resultados óptimos se recomienda uso durante al menos 6 meses.
- LUMINOSA + DIFUMINADA (Día): Durante el día, LUMINOSA está diseñado para contribuir al reequilibrio de la microbiota intestinal mediante 150 mil millones de microorganismos que pueden ayudar a modular la inflamación sistémica y reducir brotes desde el origen.
- Simultáneamente, DIFUMINADA aporta 9 antioxidantes específicos que contribuyen a la fotoprotección natural, ayudan a difuminar manchas existentes y protegen contra el daño oxidativo que podría generar nueva hiperpigmentación.
- HIDRATADA (Noche): Por la noche, cuando la piel realiza sus procesos más importantes de reparación, HIDRATADA contribuye a la regeneración profunda mediante ceramidas que refuerzan la barrera cutánea, ácido hialurónico que favorece la hidratación, y melatonina que puede ayudar a optimizar los ciclos de renovación celular nocturna.
No hay resultados

- Personas con acné leve a moderado activo que también experimentan hiperpigmentación post-inflamatoria, manchas o marcas persistentes, y buscan un protocolo integral que contribuya a abordar tanto la prevención de brotes como la reparación de secuelas desde múltiples frentes.
- Personas que han probado múltiples tratamientos tópicos sin obtener resultados duraderos y desean un enfoque que actúe desde el origen intestinal mientras protege y regenera la piel de manera natural, sin depender exclusivamente de productos externos agresivos.
- Adultos entre 25-45 años con piel mixta o grasa propensa a brotes que además notan pérdida de firmeza, deshidratación o sensibilidad, y buscan contribuir al equilibrio de su piel de forma integral respetando los ritmos naturales día-noche de la piel.
- Personas que experimentan brotes que podrían estar relacionados con estrés, cambios hormonales, desequilibrios digestivos o falta de sueño reparador, y desean abordar la conexión intestino-piel mientras optimizan la regeneración nocturna de manera sostenible y científicamente respaldada.
- Quienes buscan un protocolo estructurado de uso prolongado que contribuya a transformar su piel gradualmente mediante un enfoque de tres productos complementarios diseñados para trabajar sinérgicamente en diferentes momentos del día, priorizando resultados duraderos sobre soluciones rápidas.



¿NECESITO TOMARLO DE FORMA CONTINUA?
Sí, para obtener resultados sostenidos. Nuestros nutricosméticos están formulados para trabajar progresivamente. Recomendamos un mínimo de 6 meses de uso continuado para transformar la piel de forma profunda y estable.
¿PUEDO TOMARLA SI ESTOY EMBARAZADA O EN PERÍODO DE LACTANCIA?
Siempre consultar primero con tu médico antes de tomar cualquier suplemento (incluidos los nuestros). Aunque nuestros nutricosméticos están formulados con activos naturales y seguros en condiciones normales, durante el embarazo y la lactancia las necesidades y sensibilidades del cuerpo cambian. La seguridad de tu bebé y tu bienestar son lo primero. Si estás en estas etapas tan especiales, te animamos a hablarlo con tu profesional de confianza para valorar lo mejor para ti.
¿HAY EFECTO REBOTE SI DEJO DE TOMARLA?
No, no existe efecto rebote. Simplemente, el cuerpo volverá poco a poco a su punto de partida, igual que pasaría si dejas de la noche a la mañana tu rutina cosmética normal. Tu rostro, en un mes, podría perder elasticidad, luminosidad, estar más reseco. Por eso recomendamos integrarlos como parte de un cuidado extra a la piel de forma continuada y no temporal. La clave está en la continuidad.
¿SE PUEDEN TOMAR SI ESTOY USANDO TRATAMIENTOS DERMATOLÓGICOS?
Nuestros suplementos trabajan desde la nutrición interna y no interfieren con tratamientos tópicos como retinoides, peróxido de benzoilo o ácido salicílico. Si estás bajo tratamiento oral específico (como isotretinoína o espironolactona), te recomendamos consultar con tu dermatólogo o revisar las contraindicaciones del tratamiento que estés tomando por si alguno de los activos no es compatible con tu tratamiento actual.
Activos
| Ingrediente | Dosis | VRN |
|---|---|---|
| Lactobacillus Acidophilus | 9,15 × 10⁸ UFC | |
| Lactobacillus Rhamnosus | 9,15 × 10⁸ UFC | |
| Lactobacillus Plantarum | 5,49 × 10⁸ UFC | |
| Bifidobacterium Animalis Subsp, Lactis | 7,32 × 10⁸ UFC | |
| Bifidobacterium Bifidum | 1,46 × 10¹¹ UFC | |
| Lactobacillus Reuteri | 5,49 × 10⁸ UFC | |
| Niacina (Vitamina B3) | 25 mg NE | 156,25% |
| Retinol Acetato (Vitamina A) | 1600 μg RE | 200% |
| Clorhidrato de Piridoxina (Vitamina B6) | 3 mg | 214,28% |
| Biotina | 50 μg | 100% |
| Riboflavina (Vitamina B2) | 1,4 mg | 100% |
| Ácido Pantoténico (Vitamina B5) | 12 mg | 200% |
| Zinc (Gluconato de Zinc) | 15 mg | 150% |
| Cobre (Gluconato de Cobre) | 2 mg | 200% |
| Selenio (Selenito de Sodio) | 100 μg | 181,80% |
| Extracto de Fruto de Schisandra | 150 mg | |
| Astaxantina | 60 mg | |
| Extracto de Raíz de Helecho (Polypodium Leucotomos) | 250 mg | |
| Extractos de Semillas de Uva Roja de Origen Español (Vitis Vinifera) | 100 mg | |
| Extractos de Semillas de Uva Blanca de Origen Español (Vitis Vinifera) | 100 mg | |
| Extracto de Corteza de Pino Marítimo Francés (Pinus Pinaster) | 50 mg | |
| Oleorresina Rica en Astaxantina | 40 mg | |
| Ácido L-Ascórbico (Vitamina C) | 80 mg | 100% |
| Acetato de Dl-Alfa Tocoferilo (Vitamina E) | 12 mg α-TE | 100% |
| Betacaroteno (Vitamina A) | 3000 μg RE | 375% |
| Gluconato de Zinc | 5 mg | 50% |
| Ceramidas Ceramosides™ | 30 mg | |
| Ácido Hialurónico | 100 mg | |
| Melatonina | 300 μg | |
| Hoja de Aloe Vera en Polvo | 25 mg | |
| Ashwagandha | 200 mg | |
| Extracto de semillas de uva roja de origen español (vitis vinifera) | 100 mg | 150% |
| Extracto de semillas de uva blanca de origen español (vitis vinifera) | 100 mg | |
| Extracto de corteza de pino marítimo francés (pinus pinaster) | 50 mg | |
| Oleorresina rica en astaxantina | 40 mg | |
| Ácido L-ascórbico (vitamina c) | 80 mg | 100% |
| Acetato de DL-alfa tocoferilo (vitamina e) | 12 mg α-TE | 100% |
| Betacaroteno (vitamina a) | 3000 μg RE | 375% |
| Gluconato de zinc | 5 mg | 50% |




























